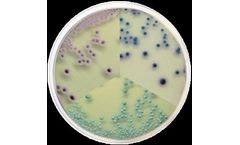
Condalab - Model 2207 - Candida Chromogenic Agar
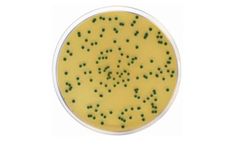
Condalab - Model ISO- 1446 - Chromogenic Cronobacter Isolation Agar (CCI)

- Home
- Equipment
Refine by
Condalab Environmental Equipment & Supplies
6 equipment items found
Manufactured by:Condalab based inTorrejón de Ardoz, SPAIN
Selective medium for the simultaneous detection of E. coli and other coliforms in water ...
Manufactured by:Condalab based inTorrejón de Ardoz, SPAIN
Medium for fibrous ...
Manufactured by:Condalab based inTorrejón de Ardoz, SPAIN
Gelling agent for culture ...
Manufactured by:Condalab based inTorrejón de Ardoz, SPAIN
Differential and selective chromogenic medium for the isolation and quick identification of Candida spp. of clinical ...
Manufactured by:Condalab based inTorrejón de Ardoz, SPAIN
For the isolation of presumptive Cronobacter spp. in food products and environmental ...
Manufactured by:Condalab based inTorrejón de Ardoz, SPAIN
For the cultivation of recombinant strains of E.coli and for growth of filamentous ...